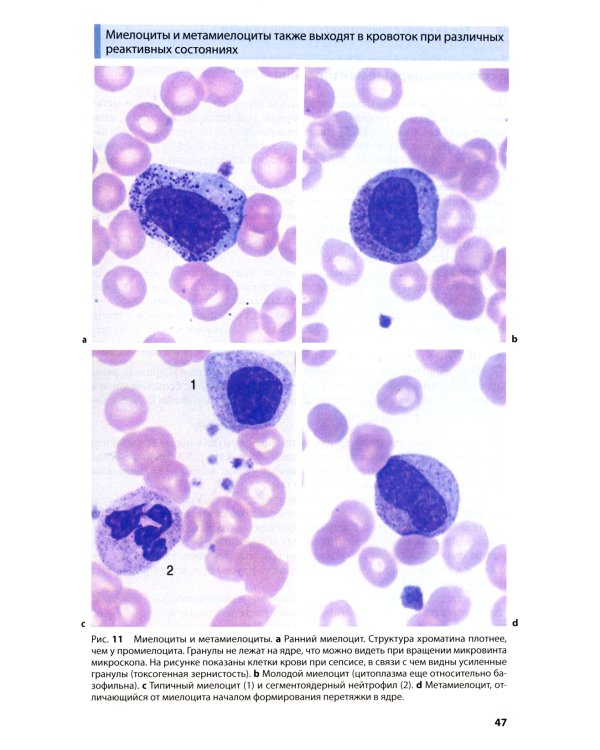
Атлас по гематологии. Практическое пособие по морфологической и клинической диагностике. 4-е изд

Аннотация: Атлас по гематологии. Практическое пособие по морфологической и клинической диагностике. 4-е изд
| Издательство | МЕДпресс-информ |
| Автор/составитель | Тэмл Харальд;Диам Хайнц;Хаферлах Торстен |
| Год выпуска | 2021 |
| Кол-во страниц | 208 |
| ISBN | 978-5-00030-895-0 |
| Обложка | мягкая обложка |
| Вес | 263г |
| Формат | 14 x 22 cm |
| Возрастная категория | 16+ |
| Дата выпуска | 2021 г. |
| Издание | 4 |
| Количество томов | 1 |
| Количество страниц | 208 |
| Переплет | мягкий |
| Размеры | 210x145 мм |
| Стандарт | 16 |
| Вес | 220 |
В атласе рассмотрена морфология клеток крови в норме и при различных патологических состояниях. В нем также содержатся элементарные сведения по выполнению и трактовке результатов цитологического исследования костного мозга, лимфатических узлов, других органов и тканей. Атлас иллюстрирован информативными микрофотографиями, которые сопровождаются пояснениями, основанными на современных принципах и критериях морфологической классификации. Нозология и дифференциальная диагностика болезней системы крови нашли свое отражение в соответствующих таблицах. Структура представленного в атласе материала базируется на системном подходе к различным разделам лабораторной гематологии. Издание будет полезно врачам-лаборантам, врачам общей практики и студентам медицинских вузов старших курсов.
Читать далее →
Бесплатная Доставка по Европе (EU)*
*Для заказов свыше 40,- евро Подробнее
Атлас по гематологии. Практическое пособие по морфологической и клинической диагностике. 4-е изд
-37%- Производитель: МЕДпресс-информ
- Модель: TEEI9848850
- ISBN 978-5-00030-895-0
-
Наличие:
Есть в наличии
93.44€
-37%
58.87€
Нашли этот товар по более низкой цене?
Во-первых - Вы молодец!
Во-первых - Вы молодец!
Просим Вас сообщить нам:


 Google
Google